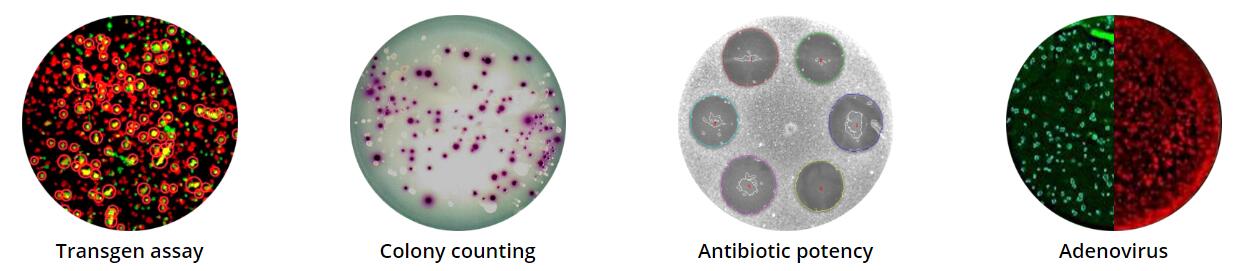

| 產品名稱 | 酶聯免疫斑點圖像分析系統, 7000 , 3000, 4000, 5000, 6000 |
| 品牌 | 德國 |
| 產品貨號 | 酶聯免疫斑點圖像分析系統, 7000 , 3000, 4000, 5000, 6000 |
| 中國授權代理服務商 | 世聯博研(北京)科技有限公司 |
| 聯系人 | 李先生 |
| 聯系電話 | 18618101725 |
產品說明德國酶聯免疫斑點圖像分析系統德國由化學家兼工程師創建于1986年,專注于 EliSpot酶聯免疫斑點計數和定量自動化檢測分析設備30多年,公司的專利立體3D雙光照明(增強斑點與背景的對比度,有效抑制板孔側壁反光造成的“幻影現象”,提高檢測精度度),wei依能進行單斑點、每孔光密度測定以定量細胞因子分泌的照明系統,解決了ELISPOT斑點計數的快速化,標準化和斑點信息的詳細化,并且可以對細胞因子進行定量分析,是wei依能進行單斑點、每孔光密度測定以定量細胞因子分泌的照明系統,獲得應用于ELISPOT斑點識別的3D雙光源專利技術,shou次實現對ELISPOT膜板和ELISPOT透明板的良好識別,弟一個采用改進機械結構的前置式載物臺和自動開關密閉檢測室,同一孔中同時識別多至12色ELISPOT斑點,shou次實現熒光ELISPOT檢測,歐盟科技項目,產品成熟,30年歷史,1000多家實驗室使用,國內近百家單位使用,已成為熒光/Elispot酶聯免疫斑點檢測分析的黃jin標準。
酶聯免疫斑點圖像計數和分析產品特點:●專利立體3D雙光照明系統:
增強斑點與背景的對比度,有效抑制板孔側壁反光造成的“幻影現象”,提高檢測精度度。能進行單斑點、每孔光密度測定以定量細胞因子分泌的照明系統。
高分辨率2340×2000 分辨率SONY fire wire真彩數碼成像系統,可進行雙色或三色Elispot實驗結果的檢測。也適用于病毒斑(Viral Plaque)、克隆形成(CFU)、腫瘤細胞集落形成(HTCFA),干細胞集落形成試驗等。 數據量高達5M 的圖像數據(單孔)﹑雙色以上的圖像分析功能, 一體化HP 20’ 液晶顯示器. 采用高精度齒輪步進電機,避免了皮帶輪步進電機的打滑和老化,定位精度<0.01mm。
高精度微步進電機、齒輪傳動方式、樣品架移動精度< 0.01mm
適用各種載玻片、35-100mm培養碟、6 / 12 / 24 / 48 / 96/384孔各型培養板。對于實驗室常用的U-Cytech、MILLIPORE、NUNC、 Whatman、Greiner等公司的透明培養板、不透明(白色)培養板、以及PVDF膜培養板均適用。
需進行不同類型培養板的檢測時,wu須手動調焦,轉換更為方便。
動態“像素周圍識別”,模糊、彌散、過大、過小斑點以及高背景或不規則背景均可檢測。
每孔可檢測多至2000個斑點,直徑>3?m 的斑點即可被有效檢測(通常設定檢測的斑點大小為20-50?m)。
尤其針對透明板、白色PVDF板,可有效識別板孔邊緣,保證整個板孔的計數精度。
應用ELISA透光測量原理,可對每個斑點,每個孔進行光密度值測定,定量分析細胞因子分泌。
對于背景重的培養板孔可進行自動背景補償調節。
已經過MABTECH, U-Cytech, Diaclone, Pharmingen, R&D等公司ELISPOT產品的驗證,測量結果可信度高。
用戶可根據試驗情況設置斑點識別參數,直接重新分析已掃描數據,不必重復掃描。相同參數下分析結果可重復性為+/-零誤差。
直觀的板孔選擇界面,可輕松進行單孔、任意孔區域、quan板掃描。
用戶可手動選擇需去除的斑點,自定義需去除的破損區域或wu法識別區域,測量結果更精度可信。
包括培養孔原始數據如每孔斑點數、斑點幾何形狀(直徑、圓度、曲率、毛糙度)參數、每個斑點坐標、光密度(提示細胞因子量)等以及樣本均數、方差、統計學分布等多種統計數據和分析圖表。
可將整板圖像,單孔圖像,每孔斑點數,斑點詳細數據、分布、和統計學分析結果直接輸出到Word、Excel、Powerpoint。可選擇HTML,
BMP, JPEG, PDF等多種格式。 ●歷史悠久,產品成熟度高、文獻量大: 30多年歷史驗證,1500多個實驗室成功使用,國內有50多的單位成功使用,wu技術和應用風險。
應用范圍:德國公司專利產品,該EliSpot Reader是針對35-100mm培養碟、載片、6-384孔多孔板和微量培養板的自動檢測和分析儀器。適用于目前實驗室常用的各種專用培養板上酶聯斑點(Elispot)、病毒斑( Viral Plaque)、克隆形成(CFU)、腫瘤細胞集落形成(HTCFA),干細胞集落形成試驗等實驗結果的分析。
單細胞解析度/體外抗原特異性T細胞頻率的準確測量,細胞因子協同表達/雙色ELISPOT,腫瘤免疫,T細胞功能研究,移植免疫等;對探索免疫系統疾病的發病機制和腫瘤免疫細胞治療評價具有重要意義。
| |